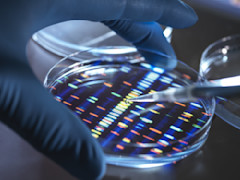

temi individuati simultaneamente
Cogliere i temi appena emergono
Dynamic Theme Machine è una strategia tematica quantitativa che si avvale dell’intelligenza artificiale (IA) per individuare e investire in temi consolidati ed emergenti. La strategia ruota dinamicamente tra i temi, acquistando quelli interessanti e vendendo quelli in declino.
- ~100
- ~25
temi detenuti nel fondo
- >100K
testi utilizzati per trovare i temi
Perché investire in Dynamic Theme Machine?
I temi possono determinare l’andamento dei mercati azionari, ma non tutti i temi sono sempre validi. Alcuni temi sono interessanti, mentre altri perdono forza. Questa strategia permette di accedere ai temi interessanti, evitando quelli in declino.
Temi principali
I temi principali del portafoglio, classificati per ponderazione attiva, sono:

Pubblicità digitale e streaming
Il 70% circa della spesa pubblicitaria a livello mondiale è destinata ai canali digitali e questa percentuale continua a crescere, poiché i brand si accorgono di poter raggiungere meglio i clienti. Nel settore dello streaming, con la fine delle “guerre dello streaming” scoppiate durante la pandemia, si stanno affermando alcune aziende dominanti.



Intelligenza artificiale e tecnologie cloud
L’intelligenza artificiale (IA) si sta diffondendo in molti settori, con un aumento degli investimenti che premia i produttori di chip. Le imprese di software, dal canto loro, stanno incorporando modelli di IA nei loro prodotti per migliorarne la funzionalità. Al tempo stesso, i sistemi informatici continuano a migrare dall’infrastruttura locale al cloud.

Trattamenti oncologici
Il cancro è la causa di quasi un decesso su sei a livello globale e si stanno compiendo grandi progressi in campo medico per individuare e trattare molte forme di tumore. La diagnosi precoce in ambito oncologico può essere particolarmente utile per allungare la vita dei pazienti e migliorarne la qualità.

Salute mentale e neurologia
Le malattie mentali stanno diventando più frequenti, ma vengono anche diagnosticate più efficacemente quale risultato dell’invecchiamento demografico, delle pressioni della società e del superamento dei tabù sociali. I finanziamenti sono in aumento e le imprese stanno facendo passi avanti nel fornire trattamenti ai pazienti.

Tecnologia e ricerca biologica
Questo tema comprende vari sviluppi, tra cui i trattamenti di nuova generazione per l’HIV, il passaggio dalle molecole di piccole dimensioni ai farmaci biologici, nonché le cure per le malattie infettive.
Altri temi
Il fondo è esposto anche ai seguenti temi:
Medicina genetica
Secondo le previsioni, l’editing genomico diventerà un mercato da 30 miliardi di dollari entro il 2030. Nel 2023 gli Stati Uniti hanno approvato la prima terapia genica. I costi del sequenziamento del genoma sono scesi da 1.200 dollari nel 2015 a 500 dollari nel 2024.

Comunicazioni satellitari
Oggi i satelliti possono collegarsi direttamente ai telefoni cellulari e tra qualche anno ottenere dati dai satelliti sarà alla portata di tutti. Il numero di lanci orbitali riusciti è più che raddoppiato, passando da 114 nel 2020 a 263 nel 2024.

Giochi immersivi
I dispositivi di realtà aumentata continuano a migliorare e trovano una crescente diffusione presso i consumatori. Negli ultimi due anni Ray-Ban e Meta hanno venduto oltre 2 milioni di occhiali intelligenti. Tuttavia, la realtà virtuale è ancora agli inizi.

Veicoli autonomi
Negli Stati Uniti il numero di corse in taxi senza conducente è più che raddoppiato nell’ultimo anno, raggiungendo le 200.000 settimanali, segno che la tecnologia di guida autonoma si sta facendo strada nel mondo reale.

Viaggi e tempo libero
Un numero crescente di consumatori, soprattutto giovani, preferisce le esperienze ai beni materiali, e questo si traduce in un aumento della spesa per viaggi e tempo libero. Anche le generazioni anziane, tra cui i boomer, spendono di più, poiché vanno in pensione in buona salute e in stato di agiatezza.
La strategia
Il processo di investimento di Dynamic Theme Machine si articola in tre parti. In primo luogo, individuiamo i temi da una grande mole di dati, tra cui le call sugli utili delle società, gli articoli di giornale e le interviste ai dirigenti, utilizzando una forma di IA chiamata elaborazione del linguaggio naturale. In secondo luogo, utilizziamo l’analisi del sentiment (un processo che determina se un testo è positivo, negativo o neutro sulla base dei vocaboli utilizzati) per selezionare le imprese più interessanti. In terzo luogo, investiamo nei temi selezionati e nei loro beneficiari utilizzando i modelli quantitativi di Robeco.
Nello specifico, avvalendoci del nostro processo di ottimizzazione quantitativa, costruiamo un portafoglio di circa 25 temi e 100 titoli. Il portafoglio si caratterizza per una buona esposizione fattoriale e un rischio controllato, con un tracking error del 5% circa (fonte: Robeco).
La strategia permette ai clienti di investire con un’esposizione bilanciata in temi emergenti e consolidati grazie all’utilizzo dell’IA e di modelli quantitativi collaudati, sotto la supervisione dei solidi team quantitativi e tematici di Robeco.
Dynamic Theme Machine UCITS ETF USD Acc
- performance ytd (28-2)
- -3,20%
- SFDR (28-2)
- Article 8
- Pagamento del dividendo (28-2)
- No
- Prezzo corrente (31-3)
- 5,48
- Inception date (28-2)
La gamma di ETF attivi di Robeco
Scopri come gli ETF attivi di Robeco possono arricchire il tuo portafoglio.
Questo video non è disponibile in quanto non hai ancora accettato i nostri cookie pubblicitari. Se li accetti, sarai in grado di visualizzare tutti i contenuti:
Processo di investimento


Link rapidi
Contatti
Rivolgiti al nostro team per scoprire come gli ETF di Robeco possono rafforzare il tuo portafoglio.














